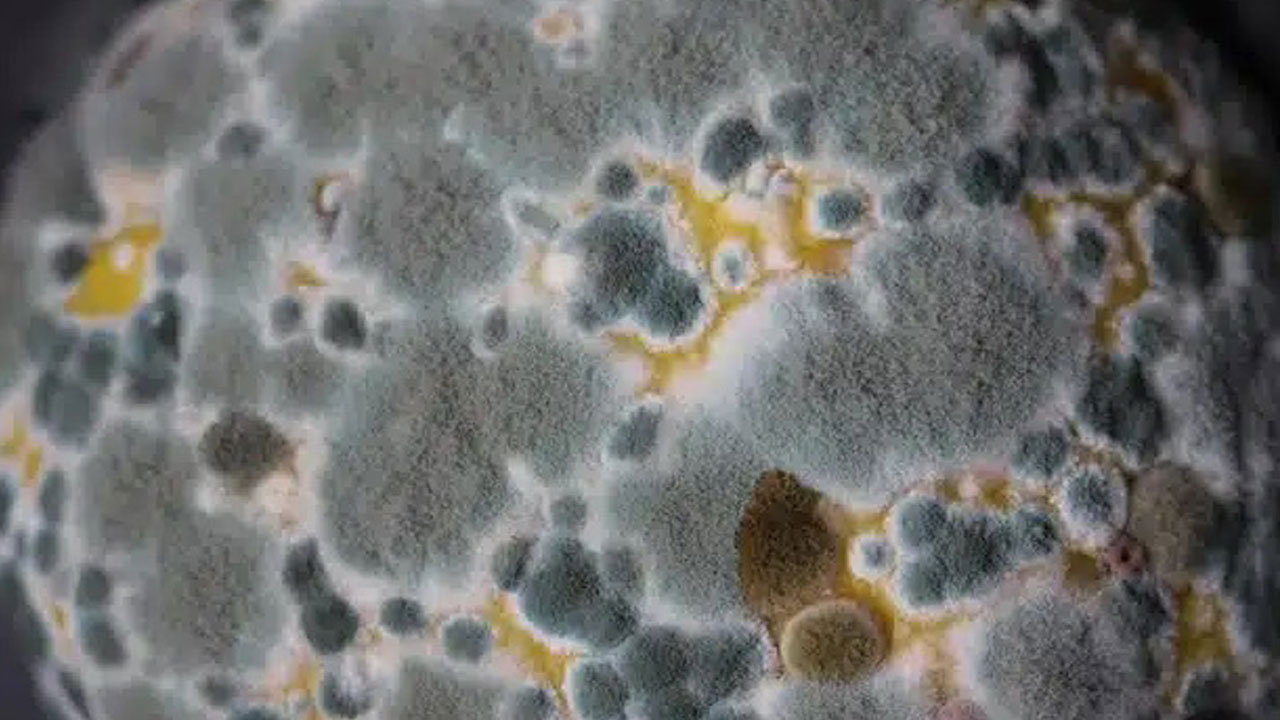
Foto - Sessiz tehlike Avrupa'ya yaklaşıyor! Ölümcül mantar sınır tanımıyor

Mantarlar için ayaklar adeta ideal bir barınaktır. Çünkü mantar hücreleri, derideki küçük çatlakları kullanarak cilt yüzeyine kolayca yerleşebilir. Üstelik ayakkabı ve çorapların oluşturduğu karanlık, sıcak ve nemli ortam mantarların çoğalması için oldukça elverişlidir. Ancak daha ciddi tehlike, küf tipi mantarların solunum yoluyla akciğerlere ulaşmasıyla ortaya çıkar. Özellikle bağışıklık sistemi zayıf olan bireylerde, bu mantar sporları akciğer dokusuna yerleşerek ciddi hastalıklara yol açabilir. BBC’ye konuşan Exeter Üniversitesi’nden Prof. Adilia Warris, "Havadaki sporlar akciğerlere ulaştığında, burada gelişip 'ekmek benzeri' yapılara dönüşebilir ve enfeksiyona neden olabilir" açıklamasını yapıyor. Mantar kaynaklı tehdit sadece dış çevreyle sınırlı değil. Aslında bazı mantar türleri halihazırda vücudumuzda bulunuyor. Örneğin; candida albicans adlı maya, çoğu sağlıklı bireyin bağırsak florasında yer alan bir mikroorganizma. Prof. Warris, bu mantarın yararlı bakterilerle birlikte bağırsak sağlığının korunmasında rol oynadığını belirtiyor. Ancak bu denge bozulduğunda, örneğin bağışıklık sistemi zayıfladığında ya da cerrahi müdahale sonrası vücutta hasar oluştuğunda candida gibi mantarlar kana karışarak hayati risk oluşturabilecek enfeksiyonlara neden olabiliyor. Prof. Warris, "Bu durumda septisemiye benzer, ciddi bir tablo gelişebilir" uyarısında bulunuyor. Mantarların çoğu uzun süredir çevremizde. Peki, o zaman neden şimdi daha büyük bir tehdit haline geldiler? Cevap, iklim değişikliğinden sağlık sistemlerine kadar uzanan karmaşık nedenler zincirinde gizli.